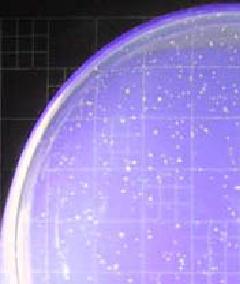

ここから本文です。
汚染指標菌検査
最終更新日 2024年4月2日
汚染指標菌とは
食品や調理器具、手指などの微生物の汚染状況を把握したり、衛生管理の適否を客観的に評価するために検査されるものです。
汚染指標菌には「一般生菌数」、「大腸菌群」、「大腸菌」などがあります。
これらの菌を調べることにより、汚染の度合いや病原菌の有無を推測することができます。
一般生菌数
標準寒天培地中のコロニー
食品中に存在する、好気的(酸素を必要とする)状態で、35℃で培養して検出される細菌の数をいいます。
この一般生菌数の多少は、食品及びそれらが生産された環境全般の細菌汚染状況を反映し、また、食品を介して起こる感染症の原因菌のほとんどが35℃前後でよく発育することから、食品の安全性、保存性、衛生的取扱いの適否を総合的に評価する際にきわめて有力な指標となります。
一般生菌数は安全性を直接指し示すものではありませんが、一般生菌数が多い場合は、病原菌の存在、さらにはそれらの細菌が増殖している可能性のあることを示します。
検査法
標準寒天培地を用い、発育したコロニーを全てカウントし、食品1gあたりの一般生菌数を算出します。
大腸菌群

デソキシコーレイト寒天培地中の大腸菌群
飲料水等では糞便汚染の指標としてとらえられますが、食品においては主に加熱の指標とされています。
- 大腸菌群の成分規格が設定されている食品
- 乳、乳製品、清涼飲料水、氷雪
- 加熱食肉製品(包装後加熱)、魚肉練り製品
- 無加熱摂取冷凍食品
- 凍結直前に加熱された加熱後摂取冷凍食品
- 氷菓
- 冷凍ゆでだこ、鯨肉製品
検査法
- デソキシコーレイト寒天培地を用いた方法(氷菓など)
培養後暗赤色のコロニーを認めた場合は推定試験陽性とし、EMB培地で確定試験、乳糖ブイヨン及びグラム染色で完全試験を実施します。
- BGLB培地、LB培地を用いた方法(清涼飲料水、魚肉練り製品など)
発酵管を入れた培地に試料液を加え培養し、ガスを発生した場合は、確定試験、完全試験を実施します。
大腸菌(E.coli)
これらは、大腸菌群に比較してヒト及び動物の糞便に存在する確率が高く、しかも自然界で死滅しやすいことから、直接又は間接的に、比較的新しい糞便汚染があったことを意味し、検出された場合、腸管系病原菌の汚染の可能性が高いといえます。
自然界からの汚染がそのまま反映される生野菜、生肉、魚介類などの未加熱食品に適用されます。
- 大腸菌の成分規格が設定されている食品
- 食肉製品の一部、生食用カキ
- 凍結直前未加熱の加熱後摂取冷凍食品
ただし、これらの規格に定められた大腸菌とは、正確には糞便系大腸菌群のことです。
検査法
EC培地を用い、ガスの産生により判定します。ガス産生の場合、確定試験、完全試験を実施する場合もあります。
その他の汚染指標菌
その他の汚染指標菌としては「腸球菌・低温細菌・高温細菌・芽胞菌」などがあります。
このページへのお問合せ
医療局健康安全部中央卸売市場本場食品衛生検査所
電話:045-441-1153
電話:045-441-1153
ファクス:045-441-8009
メールアドレス:ir-honjo@city.yokohama.lg.jp
ページID:388-580-172







